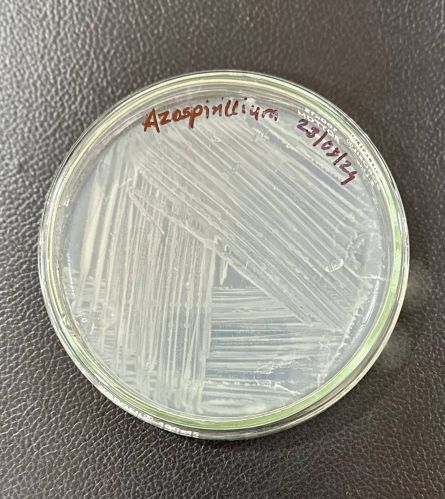
Azospirillum Biofertilizer, Classification : Biofertilzier

Company Information
Ask for more detail from the seller
Contact SupplierFormulation Type:Carrier based
Available Forms:Liquid, Powder, Granular
Viable Cell Count:1 × 10⁹ CFU/g or CFU/ml
Target Use:Nitrogen Fixation
Packing:25 Lit, 50 Kg
Advantages:-